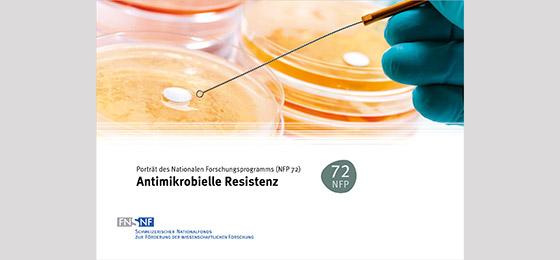

17 neue Projekte, kurz und bündig
Die neuen Projekte des NFP 72 stellen sich – gemeinsam mit allen anderen – im Programmportrait vor. Allgemein verständlich und auf den Punkt gebracht.
Von den neuen Projekten folgten zwölf aus der zweiten Ausschreibung des NFP 72. Sie untersuchen Übertragungswege von Resistenzen über die Bereiche Mensch, Tier und Umwelt hinweg, entwickeln neue Diagnostikmethoden und erproben Interventionen mit dem Ziel, dass Fachleute sowie Konsumentinnen und Konsumenten gezielter und nachhaltiger mit Antibiotika umgehen.
Fünf weitere Projekte gingen aus der fünften Ausschreibung der internationalen Joint Programming Initiative Antimicrobial Resistance JPIAMR hervor. Sie untersuchen in Zusammenarbeit mit Wissenschaftlern aus anderen Ländern neue Lösungsansätze für die human- und tiermedizinische Praxis, entwickeln Ansätze zur Verbesserung von Gesundheitssystemen und testen alternative wirtschaftliche Anreize zur Entwicklung und zum nachhaltigen Gebrauch von Antibiotika.
- Programmporträt NFP 72 (PDF)
- Überblick über alle Projekte
